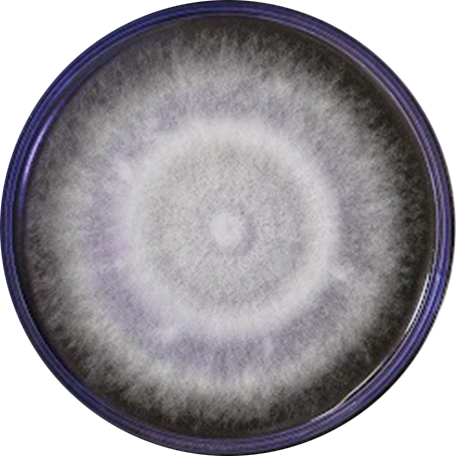

O que é controle biológico?
Um exército aliado...
Identificamos as cepas especialistas para cada linha de desenvolvimento e produzimos em larga escala através de um processo tecnológico rigoroso e inovador.
O primeiro problema que buscamos solucionar gera US$ 3,14 BILHÕES de prejuízo anualmente somente no Brasil.
O carrapato-do-boi é um dos maiores inimigos da pecuária no Brasil e no mundo.

Tratamento estratégico
O sucesso do controle biológico depende da compreensão e acompanhamento do ciclo de vida da praga. No caso do carrapato bovino Rhipicephalus (Boophilus) microplus, temos duas fases bem definidas: a fase parasitária, que ocorre enquanto o carrapato está fixado no gado, e a fase de vida livre, que ocorre quando os carrapatos estão no pasto.
A avicultura mundial enfrenta desafios no controle de insetos e ácaros que prejudicam a produção de maneira significativa.
Os cascudinhos das granjas e piolhos de galinhas são vetores de importantes patógenos para os animais e humanos e responsáveis por prejuízos relevantes.

O ácaro Varroa destructor é um ectoparasita de abelhas melíferas que acometem os apicultores globalmente.
Um dos grandes responsáveis pela queda mundial do número de abelhas.
Transmissor de diversos tipos de vírus e outros patógenos, sendo o vírus da asa deformada o mais importante.












